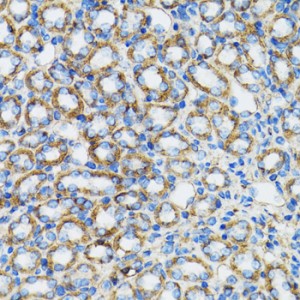
KO-Validated α-Catenin Rabbit pAb (20 μl)

KO-Validated α-Catenin Rabbit pAb (20 μl)
| Reactivity: | Human, Mouse, Rat |
| Applications: | WB, IHC, IP, ELISA |
| Host Species: | Rabbit |
| Isotype: | IgG |
| Clonality: | Polyclonal antibody |
| Gene Name: | catenin alpha 1 |
| Gene Symbol: | CTNNA1 |
| Synonyms: | MDBS2; MDPT2; CAP102; in |
| Gene ID: | 1495 |
| UniProt ID: | P35221 |
| Immunogen: | Recombinant fusion protein containing a sequence corresponding to amino acids 637-906 of human α-Catenin (NP_001894.2). |
| Dilution: | WB 1:500-1:2000; IHC 1:50-1:200 |
| Purification Method: | Affinity purification |
| Concentration: | 0.36 mg/ml |
| Buffer: | PBS with 0.02% sodium azide, 50% glycerol ,pH7.3. |
| Storage: | Store at -20°C. Avoid freeze / thaw cycles. |
| Documents: | Manual-CTNNA1 polyclonal antibody |
Background
This gene encodes a member of the catenin family of proteins that play an important role in cell adhesion process by connecting cadherins located on the plasma membrane to the actin filaments inside the cell. The encoded mechanosensing protein contains three vinculin homology domains and undergoes conformational changes in response to cytoskeletal tension, resulting in the reconfiguration of cadherin-actin filament connections. Certain mutations in this gene cause butterfly-shaped pigment dystrophy.
Images
 | Western blot analysis of various lysates using [KO Validated] α-Catenin Rabbit pAb (A5635) at 1:1000 dilution. Secondary antibody: HRP-conjugated Goat anti-Rabbit IgG (H+L) (AS014) at 1:10000 dilution. Lysates/proteins: 25μg per lane. Blocking buffer: 3% nonfat dry milk in TBST. Detection: ECL Basic Kit (RM00020). Exposure time: 60s. |
 | Western blot analysis of lysates from wild type (WT) and α-Catenin knockout (KO) 293T cells, using [KO Validated] α-Catenin Rabbit pAb (A5635) at 1:1000 dilution. Secondary antibody: HRP-conjugated Goat anti-Rabbit IgG (H+L) (AS014) at 1:10000 dilution. Lysates/proteins: 25μg per lane. Blocking buffer: 3% nonfat dry milk in TBST. Detection: ECL Basic Kit (RM00020). Exposure time: 10s. |
 | Immunohistochemistry analysis of paraffin-embedded Rat kidney using [KO Validated] α-Catenin Rabbit pAb (A5635) at dilution of 1:100 (40x lens). Microwave antigen retrieval performed with 0.01M PBS Buffer (pH 7.2) prior to IHC staining. |
 | Immunohistochemistry analysis of paraffin-embedded Human vermiform appendix using [KO Validated] α-Catenin Rabbit pAb (A5635) at dilution of 1:100 (40x lens). Microwave antigen retrieval performed with 0.01M PBS Buffer (pH 7.2) prior to IHC staining. |
 | Immunohistochemistry analysis of paraffin-embedded Human stomach using [KO Validated] α-Catenin Rabbit pAb (A5635) at dilution of 1:100 (40x lens). Microwave antigen retrieval performed with 0.01M PBS Buffer (pH 7.2) prior to IHC staining. |
 | Immunohistochemistry analysis of paraffin-embedded Mouse testis using [KO Validated] α-Catenin Rabbit pAb (A5635) at dilution of 1:100 (40x lens). Microwave antigen retrieval performed with 0.01M PBS Buffer (pH 7.2) prior to IHC staining. |
 | Immunoprecipitation analysis of 200 μg extracts of 293T cells using 3 μg α-Catenin antibody (A5635). Western blot was performed from the immunoprecipitate using α-Catenin antibody (A5635) at a dilution of 1:500. |
You may also be interested in: